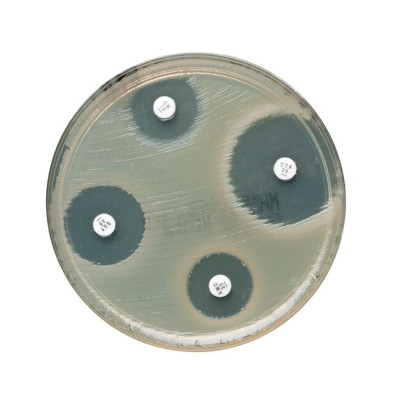
20 PLACAS AGAR MÜLLER HINTON

Contacte-nos - 210996971 - info@ibdciencia.pt
-
Utensílios
Instrumentos
Por disciplina
Aparelhos e acessórios
-
-
-
-
-
Biología
Física
Química
Geología
Outros conjuntos
-
-
Disciplina
Níveis
Click for more products.
No products were found.